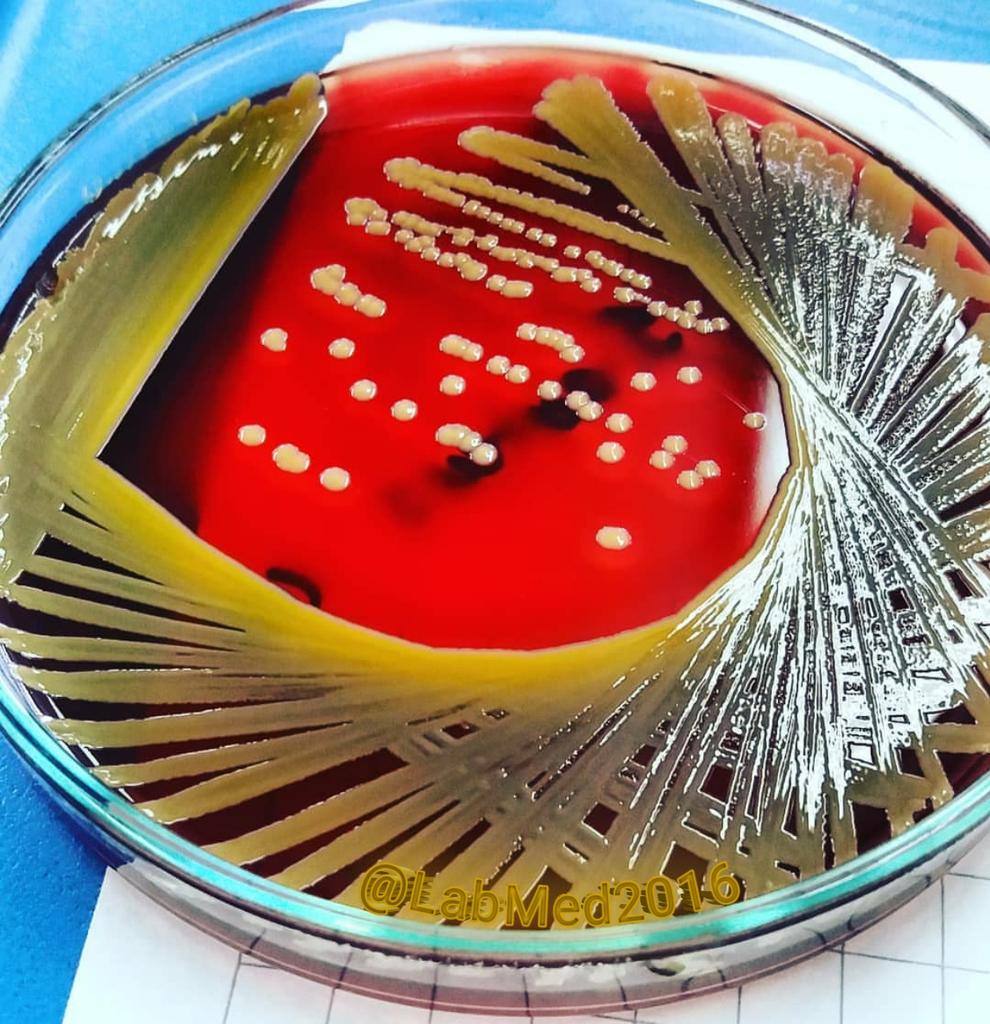
LabMed2016's tweet image. من اول مشاهدة لهذه الصورة وكانها لملعب كرة القدم التقطت من اعلى ،
لكنها في الحقيقة هي الذهبية الجميلة👈Staphylococcus aureus
زرعت على Blood Agar. 
#الطب_المخبري
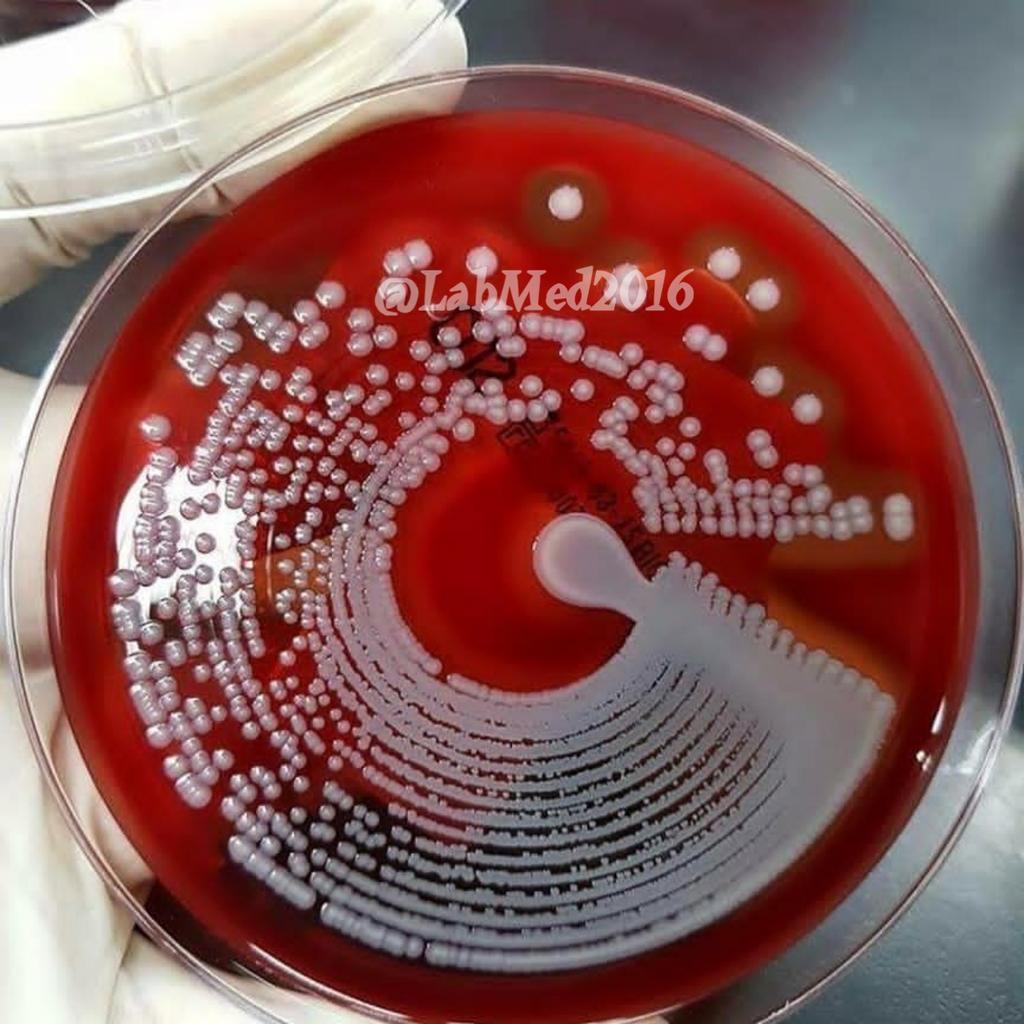
LabMed2016's tweet image. هذه الطريقة من التزريع ،استخدمت فيها تقنية حديثة تسمىPREVI ISOLA .
✅🔬 انضم إلينا: 👇
#الطب_المخبري

قد يعجبك
خمسة تحاليل يجب ان تكون فيها العينه بعيدة عن الضوء المباشر: - • Beta-carotene • Bilirubin • Porphyrins • Vitamin A • Vitamin B6

من اول مشاهدة لهذه الصورة وكانها لملعب كرة القدم التقطت من اعلى ، لكنها في الحقيقة هي الذهبية الجميلة👈Staphylococcus aureus زرعت على Blood Agar. #الطب_المخبري
هذه الطريقة من التزريع ،استخدمت فيها تقنية حديثة تسمىPREVI ISOLA . ✅🔬 انضم إلينا: 👇 #الطب_المخبري
وبسم الله نبدأ مع أول ثريد ✨👏🏻 "Electrolytes"🧪

✅کتاب📕Hematology and coagulation (2019)💥 🆔 @LabMed2016 الكتاب تجده هنا👇 t.me/LabMed2016/188…
Rodak's Hematologyكتاب ✅ الشهير بنسخته السادسة⑥ 2020 🆔 @LabMed2016 الكتاب هنا👇 t.me/LabMed2016/188…
✅ کتاب MEDICAL MICROBIOLOGY الطبعة التاسعة〖2020】حصريا ،، جاهز للتحميل في القناة 👇 t.me/LabMed2016/188…
✺تصحيح الصوديوم+Na عندما:- ① تكون نسبةالجلكوزمابين100━440مليجرام/100مل ② الجلكوز اعلى من440مليجرام/100مل ③ يرتفع البروتين🔺 ④ ترتفع الدهون🔺

✺معادلات تصحيح البوتاسيوم+K عندما :- ① تقل درجة الحموضةpH🔻 ② ترتفع الازمولالية للبلازما🔺 ③ ترتفع الصفائح الدموية🔺

✺معادلات تصحيح الكالسيومCa+² عندما : ① يقل الالبيومين 🔻 ② يرتفع الجلوبيولين🔺 ③ ترتفع درجة الحموضة🔺

تحوّل سريع جداللماءالباردالى جليدبواسطةبكتيرياسيدوموناس سيرنكا😳 ،عنداضافةبعض قطرات من البكتيريا،بسبب وجودبروتينINP #الطب_المخبري @MLS_2015
United States الاتجاهات
- 1. Ravens 48K posts
- 2. Ravens 48K posts
- 3. Lamar 38.7K posts
- 4. Joe Burrow 14.8K posts
- 5. Zay Flowers 3,442 posts
- 6. Chiefs 103K posts
- 7. Cowboys 86.5K posts
- 8. Derrick Henry 4,064 posts
- 9. #WhoDey 2,814 posts
- 10. Zac Taylor 2,401 posts
- 11. Perine 1,433 posts
- 12. #CINvsBAL 2,407 posts
- 13. Mahomes 32.2K posts
- 14. Cam Boozer 1,855 posts
- 15. Tanner Hudson 1,180 posts
- 16. Sarah Beckstrom 183K posts
- 17. AFC North 1,802 posts
- 18. Tinsley 1,552 posts
- 19. Jason Garrett N/A
- 20. Myles Murphy N/A
قد يعجبك
-
 Dr.Abdulrahman Alsulaiman
Dr.Abdulrahman Alsulaiman
@AlsulaimanA -
 CLS Dept-KSU
CLS Dept-KSU
@CLSDEPT -
 Tariq Aziz
Tariq Aziz
@trqziz -
 RENAD
RENAD
@Renad_m20 -
 أخصائي مختبر اكلنيكي
أخصائي مختبر اكلنيكي
@lab_ggh -
 عبدالله الجبرين
عبدالله الجبرين
@AALJIBREN -
 نادي علوم المختبرات الإكلينيكية 🔬
نادي علوم المختبرات الإكلينيكية 🔬
@CLS_Club -
 كوثر السحيمي ¦ Kouther Alsehemi
كوثر السحيمي ¦ Kouther Alsehemi
@Koutherfaris -
 ALI ALKHALIFAH |:| عـلـي الخـليـفـة
ALI ALKHALIFAH |:| عـلـي الخـليـفـة
@AliAl_khalifah -
 أحمد آل الرزيني
أحمد آل الرزيني
@alrziny_labs -
 𝐀𝐥𝐲𝐚𝐳𝐞𝐞𝐝 𝐇𝐮𝐬𝐬𝐞𝐢𝐧
𝐀𝐥𝐲𝐚𝐳𝐞𝐞𝐝 𝐇𝐮𝐬𝐬𝐞𝐢𝐧
@elyazeed7 -
 Haya Mansour
Haya Mansour
@haya_lab -
 cls_ksu
cls_ksu
@cls__ksu -
 الأسيل ..!*'
الأسيل ..!*'
@AlAseel_92 -
 الجمعية السعودية للكيمياء السريرية
الجمعية السعودية للكيمياء السريرية
@sa_SSCC
Something went wrong.
Something went wrong.


























































































































